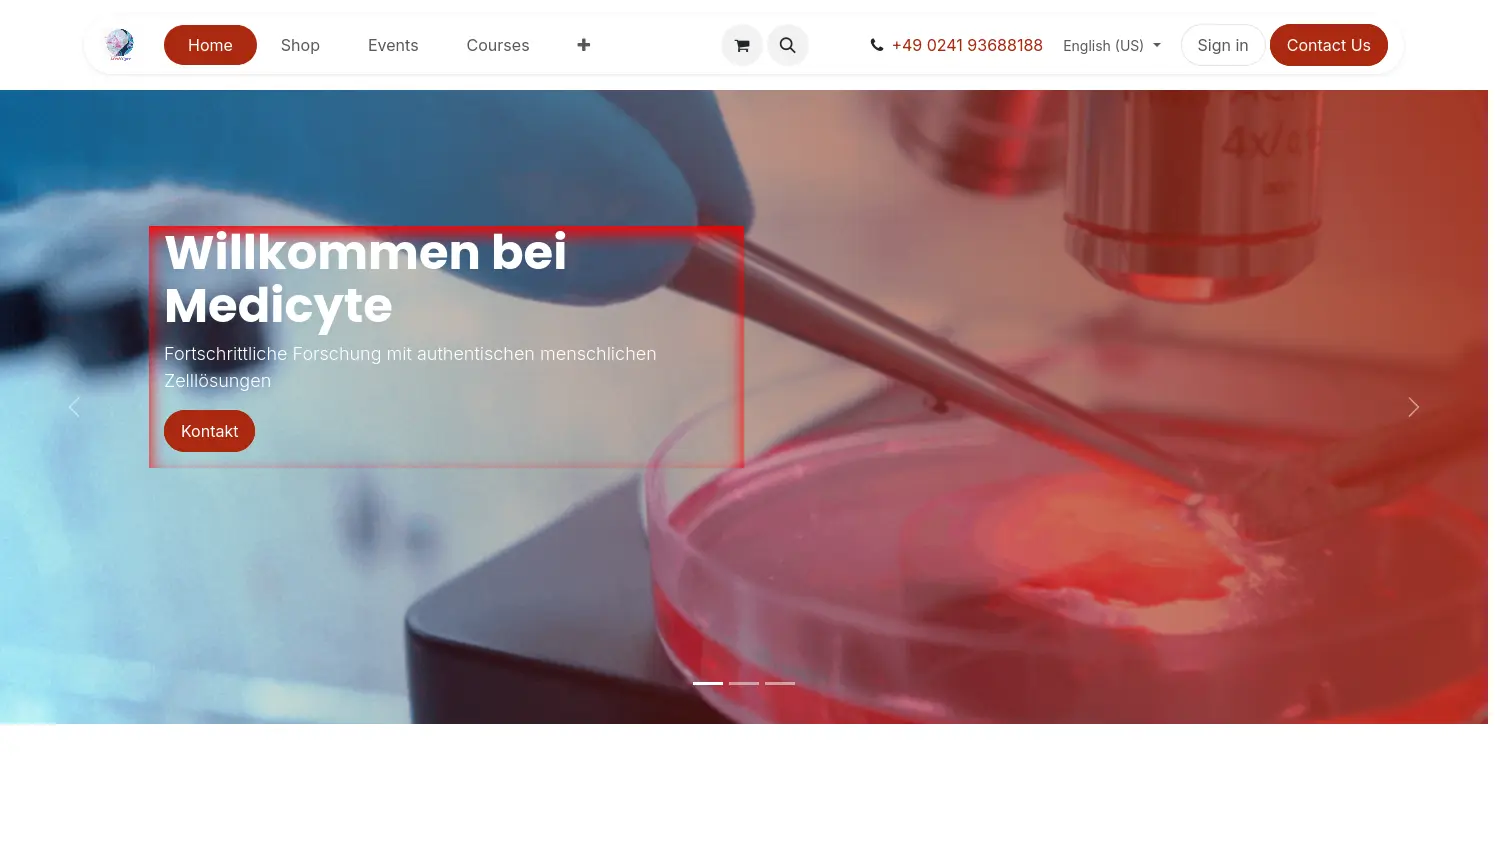
Website der Firma Medicyte

Medicyte

Fortschrittliche Forschung mit authentischen menschlichen Zelllösungen.
Medicyte ist ein spezialisiertes Biotechnologieunternehmen, das sich auf die kontrollierte, skalierbare Herstellung und Bereitstellung hochwertiger menschlicher Primärzellen konzentriert. Die Produkte dienen Forschern und Industriepartnern, um wissenschaftliche Entdeckungen voranzutreiben und innovative Therapien zu entwickeln. Medicyte engagiert sich stark für ethische Standards und die Minimierung von Tierversuchen, indem es realistische, tierversuchsfreie Zellmodelle und Kulturmedien anbietet. Durch systematische Qualitätskontrollen und lückenlose Rückverfolgbarkeit gewährleisten sie reproduzierbare und verlässliche Ergebnisse. Das Unternehmen trägt damit maßgeblich zur Weiterentwicklung der biomedizinischen Forschung und personalisierten Medizin bei.
Bitte registrieren Sie sich, oder loggen Sie sich ein, um den Website-Link der Firma zu sehen!
Über die Firma Medicyte
Medicyte ist ein führendes Biotechnologieunternehmen, das sich darauf spezialisiert hat, kontrollierte, skalierbare und standardisierte menschliche Primärzellen herzustellen. Die zentrale Mission des Unternehmens ist es, Forschern, Industriepartnern und medizinischen Fachkräften hochwertige Zellprodukte zur Verfügung zu stellen, die essenziell für wissenschaftliche Durchbrüche und die Entwicklung innovativer Therapien sind. Durch die Nutzung authentischer Zellmodelle trägt Medicyte dazu bei, die Abhängigkeit von Tiermodellen signifikant zu reduzieren und gleichzeitig die Reproduzierbarkeit und Verlässlichkeit von Forschungsergebnissen zu steigern.
Das Produktportfolio umfasst ein breites Spektrum an spezialisierten Zelltypen, darunter menschliche Fibroblasten, Epithelzellen, Endothelzellen und verschiedene Immunzellen wie Lymphozyten und Makrophagen. Diese Zelllösungen sind unverzichtbar für Anwendungen in der biomedizinischen Forschung, der Arzneimittelentwicklung, der personalisierten Medizin sowie in der Zell- und Regenerationstherapie. Medicyte strebt danach, seine proprietären Technologien als Goldstandard für menschliche Primärzellen und zellbasierte Produkte global zu etablieren, um weltweit die bevorzugte Quelle für qualitativ hochwertige menschliche Zellen zu werden.
Die Qualität der Produkte wird durch strenge Standards und ein klares ethisches Engagement untermauert. Dies beinhaltet systematische Qualitätskontrollen, standardisierte Prozesse (SOPs), lückenlose Rückverfolgbarkeit vom Spender bis zum Endprodukt und Zertifizierungen nach internationalen Standards. Das Unternehmen hält sich strikt an höchste ethische und regulatorische Vorgaben, einschließlich der informierten Einwilligung der Spender und der europäischen Gesetzgebung. Insbesondere wird das 3R-Prinzip (Replacement, Reduction, Refinement) konsequent umgesetzt, um Tierversuche durch relevantere menschliche Zellmodelle und tierfreie Kulturmedien zu ersetzen.
#Biotechnologie #Aachen #Zelltherapie #Arzneimittelentwicklung #LifeSciences #PersonalisierteMedizin #Zellkultur #RegenerativeMedizin #Tierversuchsfrei
